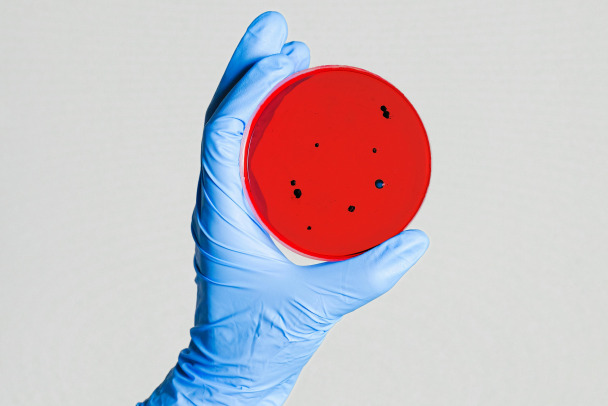

Масштабные проверки идут в школе Прионежского района Карелии, где почти у трех десятков детей выявили признаки кишечной инфекции. Один ребенок в больнице.
Как сообщает Следком Карелии 3 октября, возбуждено уголовное дело после обращения в больницу учеников Нововилговской средней школы № 3. В четверг, 2 октября, у детей появились признаки кишечной инфекции.
В статье УК речь идет об оказании услуг, не отвечающих требования безопасности и здоровья потребителей. Следователи осмотрели школьный пищеблок и другие помещения, изъяли документацию по учету продукции, продолжают допрос коллектива образовательного учреждения и работников компании, предоставляющей питание.
Глава Карелии Артур Парфенчиков рассказал, что 29 учеников начальных классов отправили на амбулаторной лечение. Предварительный диагноз — острая кишечная инфекция. В Республиканскую инфекционную больницу положили одного ребенка, "его состояние ближе к удовлетворительному".
Проверку ведет и прокуратура 10-го региона. Местное управление Роспотребнадзора приступило к эпидемиологическому расследованию.